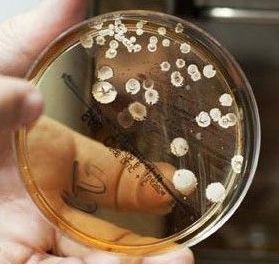

¿COMO ES LA HIDROTERAPIA SEGUN EL METODO GARRIT?
¿COMO ES LA HIDROTERAPIA SEGUN EL METODO GARRIT?
"Con la experiencia que he adquirido en los años que llevo realizando hidroterapias de colon, he desarrollado mi propio método, para obtener la maxima informacion y el mayor rendimiento de esta terapia."
Complementamos la sesión de limpieza del colon con diferentes técnicas de análisis y tratamiento:
ANALISIS DE HECES
- Realizamos un análisis de heces sobre una muestra que se obtiene durante la sesión de hidroterapia; este análisis nos da información sobre el estado de las heces, el Ph, la presencia de sangre...etc. También nos permite detectar la presencia de parásitos, hongos y bacterias que puedan estar presentes en nuestro intestino
Complementamos la sesión de limpieza del colon con diferentes técnicas de análisis y tratamiento:
ANALISIS DE HECES
- Realizamos un análisis de heces sobre una muestra que se obtiene durante la sesión de hidroterapia; este análisis nos da información sobre el estado de las heces, el Ph, la presencia de sangre...etc. También nos permite detectar la presencia de parásitos, hongos y bacterias que puedan estar presentes en nuestro intestino

TRATAMIENTO CON OZONO
- Al final de la sesión de limpieza aplicamos un tratamiento con agua ozonizada.
El ozono actúa como desinfectante natural, con lo que conseguimos eliminar un mayor numero de toxinas.
El ozono es un gas presente en la atmosfera y compuesto por tres moléculas de oxigeno. Según la OMS, el ozono es el desinfectante más eficiente para todo tipo de microorganismos. Elimina virus, bacterias y hongos
TRATAMIENTO CON OZONO
Al final de la sesión de limpieza aplicamos un tratamiento con agua ozonizada.
El ozono actúa como desinfectante natural, con lo que conseguimos eliminar un mayor numero de toxinas.
El ozono es un gas presente en la atmosfera y compuesto por tres moléculas de oxigeno. Según la OMS, el ozono es el desinfectante más eficiente para todo tipo de microorganismos. Elimina virus, bacterias y hongos

REPOBLACION DE FLORA
- Por ultimo repoblamos la flora intestinal directamente en intestino. Es importante después de una sesión de hidroterapia reponer la flora, esto normalmente se hace por via oral, al hacerlo directamente en intestino aceleramos el proceso y conseguimos una mayor efectividad.

ANALISIS DE HECES
Realizamos un análisis de heces sobre una muestra que se obtiene durante la sesión de hidroterapia; este análisis nos da información sobre el estado de las heces, el Ph, la presencia de sangre...etc. También nos permite detectar la presencia de parásitos, hongos y bacterias que puedan estar presentes en nuestro intestino


TRATAMIENTO CON OZONO
- Al final de la sesión de limpieza aplicamos un tratamiento con agua ozonizada.
El ozono actúa como desinfectante natural, con lo que conseguimos eliminar un mayor numero de toxinas.
El ozono es un gas presente en la atmosfera y compuesto por tres moléculas de oxigeno. Según la OMS, el ozono es el desinfectante más eficiente para todo tipo de microorganismos. Elimina virus, bacterias y hongos

REPOBLACION DE FLORA
Por ultimo repoblamos la flora intestinal directamente en intestino. Es importante después de una sesión de hidroterapia reponer la flora, esto normalmente se hace por via oral, al hacerlo directamente en intestino aceleramos el proceso y conseguimos una mayor efectividad.

Contáctanos
Contáctanos
DIRECCION
Centro de terapias Ismet
c/ ENTENÇA 16
08015 BCN
TELEFONO y WhatsApp
620323804
e-mail: hidroterapiagarrit@gmail.com

BUS: 46, 55, D20, H16, V9, L80 y L86.

PARADA ROCAFORT / GRAN VIA

PARADA POBLE SEC
Contáctanos
Dirección: C/ Entenza nº16, bajo 08015 Barcelona
Teléfono: 620 32 38 04
e-mail: hidroterapiagarrit@gmail.com




Parada:
Rocafort / Gran via

Parada:
Poble sec
BUS: 46, 55, D20, H16, V9, L80 y L86.
ENVIANOS UN MENSAJE
ENVIANOS UN MENSAJE
Envíanos un mensaje
Thank you for contacting us.
We will get back to you as soon as possible
We will get back to you as soon as possible
Oops, there was an error sending your message.
Please try again later
Please try again later